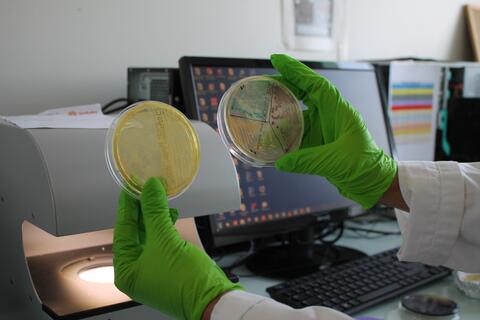

Professeur en microbiologie, biologie cellulaire et moléculaire, Hafida Khorsi-Cauet s’intéresse depuis plusieurs années aux interactions entre pesticides, immunité et inflammation. Une approche qui l’a naturellement conduite à s’investir dans la recherche sur l’endométriose, pathologie complexe aux multiples mécanismes.
En tant qu’Ambassadrice de l’exposition « La science taille XXElles – Hauts-de-France » , elle sillonne les lycées de la région pour sensibiliser les jeunes filles et le grand public à cette pathologie.
« L’endométriose est une maladie immuno-inflammatoire dans laquelle des tissus semblables à l’endomètre se développent en dehors de la cavité utérine », explique-t-elle. Fréquente mais encore insuffisamment reconnue, la maladie touche environ 10 % des femmes en âge de procréer. Elle se manifeste notamment par des douleurs menstruelles intenses, une fatigue chronique et des troubles de la fertilité.
« C’est une maladie gynécologique fréquente mais difficile à diagnostiquer, avec en moyenne 7 ans d’errance diagnostique », rappelle la chercheuse, soulignant que la sensibilisation des professionnels de santé à cette pathologie est relativement récente.
Une recherche collective au sein du laboratoire PERITOX
Au laboratoire PERITOX, la recherche sur l’endométriose s’inscrit dans une dynamique d’équipe, mobilisant chercheurs et ingénieurs autour d’une approche pluridisciplinaire. Ensemble, ils explorent la maladie à travers le projet PestiEndoMicro, qui compare des femmes atteintes d’endométriose à des femmes non atteintes afin d’identifier des signatures biologiques spécifiques.
Cette démarche repose sur une conviction scientifique forte : mieux comprendre l’endométriose nécessite de dépasser une vision uniquement gynécologique de la maladie. « Le microbiote intestinal joue un rôle déterminant dans l’immunité et donc dans l’inflammation », souligne la Pr Hafida Khorsi-Cauet.
Microbiote, immunité et inflammation : une approche systémique
Les recherches menées à l’UPJV s’intéressent particulièrement au microbiote intestinal, vaginal et endométrial, considéré comme un acteur central des mécanismes immunitaires. Un déséquilibre du microbiote, appelé dysbiose, pourrait contribuer à entretenir l’inflammation chronique observée chez les patientes.
« Le microbiote est le reflet du système immunitaire. Lorsqu’il est déséquilibré, il peut moduler la réponse immunitaire et participer aux phénomènes inflammatoires », précise la chercheuse.
Cette approche permet également d’explorer les liens entre endométriose, infertilité et inflammation, notamment à travers l’étude du microbiote génital et endométrial.
Pesticides et environnement : un axe de recherche innovant
Le projet PestiEndoMicro intègre aussi une dimension environnementale en étudiant l’impact de l’exposition chronique aux pesticides et aux perturbateurs endocriniens sur le microbiote.
Les travaux du laboratoire ont notamment mis en évidence qu’une exposition prolongée à de faibles doses de résidus de pesticides alimentaires pouvait déséquilibrer le microbiote intestinal, en favorisant des bactéries potentiellement pathogènes au détriment de bactéries bénéfiques.
« Cette dysbiose peut fragiliser la barrière intestinale, augmenter la perméabilité et s’accompagner d’une réaction inflammatoire », explique la Pr Hafida Khorsi-Cauet.
Ces résultats ouvrent de nouvelles pistes pour mieux comprendre le rôle de l’environnement dans le développement et la progression de l’endométriose.
Des outils de pointe pour mieux diagnostiquer la maladie
Pour approfondir ces recherches, l’équipe s’appuie sur des dispositifs expérimentaux innovants, dont le SHIME (Simulator of the Human Intestinal Microbial Ecosystem), un modèle d’intestin artificiel permettant d’étudier in vitro la perturbation du microbiote intestinal humain par des substances d’intérêt.

Le laboratoire dispose notamment d’un twin SHIME adulte et d’un baby SHIME, permettant d’analyser l’impact d’expositions chroniques à faibles doses de pesticides ou d’autres xénobiotiques sur l’équilibre du microbiote.
« Ces modèles constituent une alternative à l’expérimentation humaine ou animale et permettent d’évaluer l’efficacité de stratégies de prévention, notamment nutritionnelles, pour limiter les effets des pesticides sur le microbiote », souligne la chercheuse.
En parallèle, le projet s’intéresse au dosage de l’ADN libre circulant, biomarqueur du stress oxydant, afin d’établir une signature biologique de l’endométriose. Une approche prometteuse pour mieux caractériser la maladie et favoriser, à terme, des diagnostics plus précoces.


